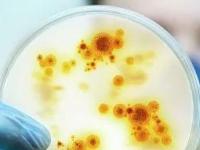
С новыми микробами! Самые страшные открытия 2019 года

Новости
Гены, которые активируются после смерти человека, обнаружили американские ученые
 16 марта 2020
16 марта 2020  2033 прочтений
2033 прочтений

По мнению некоторых ученых, смерть нельзя определять, как процесс остановки жизнедеятельности организма. Исследователи выяснили, что в человеческом организме существуют спящие гены, которые могут активироваться через несколько часов или даже дней после смерти. Однако почему и как это происходит, пока остается загадкой.
 16 марта 2020
16 марта 2020  2033 прочтений
2033 прочтенийВорота для инфекции. Встроится ли новый коронавирус в ДНК человека
 16 марта 2020
16 марта 2020  1908 прочтений
1908 прочтений

Почти восемь процентов ДНК человека приходится на фрагменты древних вирусов. Одни привели к полезным мутациям, повлиявшим на эволюцию, другие — к болезням. Изучая эти вирусные элементы, генетики доказали, что люди в прошлом не раз благополучно переживали опасные пандемии. Чем грозит нашему геному новый коронавирус — в материале ниже.
 16 марта 2020
16 марта 2020  1908 прочтений
1908 прочтенийНатуральный сексизм. Чем объясняется ранняя смерть мужчин и как в этом замешаны женские хромосомы?
 08 марта 2020
08 марта 2020  1746 прочтений
1746 прочтений

Ученые Университета Нового Южного Уэльса в Австралии выяснили, почему мужчины умирают раньше женщин. Выяснилось, что одну из важных ролей в этом играют половые хромосомы, а не склонность к курению и употреблению алкоголя, более опасная работа или неприязнь к врачам. Мы расскажем вам об исследовании, которое раскрывает загадку короткой жизни представителей мужского пола.
 08 марта 2020
08 марта 2020  1746 прочтений
1746 прочтенийУмереть с радостью. Могут ли наши последние минуты принести блаженство?
 18 февраля 2020
18 февраля 2020  2326 прочтений
2326 прочтений

В момент расставания с жизнью умирающий может испытывать огромное облегчение. Что в это время происходит в нашем сознании, в нашем организме? BBC Future пытается ответить на этот вопрос в статье из серии "Главные вопросы жизни", подготовленной совместно с сайтом The Conversation.
 18 февраля 2020
18 февраля 2020  2326 прочтений
2326 прочтенийТрупы - на удобрения: как компостируют человеческие тела
 18 февраля 2020
18 февраля 2020  2639 прочтений
2639 прочтений

Компостирование тел может стать хорошей альтернативой традиционным похоронам, считают американские специалисты. Процесс занимает всего несколько недель, требует в восемь раз меньше энергии, чем кремация, а на полученном материале можно вырастить дерево в память об усопшем.
 18 февраля 2020
18 февраля 2020  2639 прочтений
2639 прочтенийПрирожденные убийцы
 25 января 2020
25 января 2020  2009 прочтений
2009 прочтений

Китай стал очагом смертоносных эпидемий. Как вирусы появляются здесь снова и снова?
Новая эпидемия, возникшая в Китае, в очередной раз показала, что опасные вирусы, которые до поры до времени циркулируют в природе среди животных, способны стать угрозой для человеческой цивилизации. Точно неизвестно, что именно стало источником инфекции, однако люди с подобным уже сталкивались. Ниже мы расскажем о других эпидемиях, возникших похожим образом, и о том, чем они похожи на вспышку коронавируса в Китае.
Новая эпидемия, возникшая в Китае, в очередной раз показала, что опасные вирусы, которые до поры до времени циркулируют в природе среди животных, способны стать угрозой для человеческой цивилизации. Точно неизвестно, что именно стало источником инфекции, однако люди с подобным уже сталкивались. Ниже мы расскажем о других эпидемиях, возникших похожим образом, и о том, чем они похожи на вспышку коронавируса в Китае.
 25 января 2020
25 января 2020  2009 прочтений
2009 прочтенийВ леднике на Тибете обнаружены 28 неизвестных науке вирусов
 25 января 2020
25 января 2020  1799 прочтений
1799 прочтений

«Незнакомцы» мерзли высоко в горах последние 15 тысяч лет...
Вирусы стали добычей экспедиции китайских и американских ученых еще в 2015 году. Но лишь недавно стало ясно, что собственно было найдено. О чем сообщил портал LiveScience со ссылкой на библиотеку препринтов bioRxiv.
Вирусы стали добычей экспедиции китайских и американских ученых еще в 2015 году. Но лишь недавно стало ясно, что собственно было найдено. О чем сообщил портал LiveScience со ссылкой на библиотеку препринтов bioRxiv.
 25 января 2020
25 января 2020  1799 прочтений
1799 прочтенийУмер, ожил и помолодел: чудеса крионики
 13 января 2020
13 января 2020  2023 прочтений
2023 прочтений

Больного старика долго уговаривать не пришлось. Он согласился стать тем, кого наука попробует воскресить. 12 января 1967 года умер и был немедленно крионирован первый в мире человек. Это американский профессор психологии Джеймс Бедфорд. Он существует до сих пор.
За 53 года тело Бедфорда перекладывали в улучшенные капсулы и осматривали в ванне с жидким азотом: оно в хорошем состоянии, его стабильная температура –70 градусов. К нему даже подложили еще трех криопациентов. Но когда эти четверо откроют глаза, не скажет никто.
За 53 года тело Бедфорда перекладывали в улучшенные капсулы и осматривали в ванне с жидким азотом: оно в хорошем состоянии, его стабильная температура –70 градусов. К нему даже подложили еще трех криопациентов. Но когда эти четверо откроют глаза, не скажет никто.
 13 января 2020
13 января 2020  2023 прочтений
2023 прочтенийС новыми микробами! Самые страшные открытия 2019 года
 13 января 2020
13 января 2020  1596 прочтений
1596 прочтений
От болезней, вызванных устойчивыми к антибиотикам микроорганизмами, ежегодно умирает до 700 тысяч человек. К середине столетия этот показатель может вырасти до десяти миллионов, отмечают эксперты ООН. Попытки строго регламентировать продажу противомикробных препаратов и ограничить их использование в сельском хозяйстве пока эффекта не принесли. Супербактерии стремительно распространяются по миру, а ученые открывают все новые микроорганизмы, против которых бессильны даже антибиотики последнего резерва. Какие опасности грозят человечеству в новом году — в материале ниже.
 13 января 2020
13 января 2020  1596 прочтений
1596 прочтенийИз новостей
Периодические издания
Информационная рассылка:







